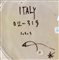

Bertolami Fine Art - Piazza Lovatelli 1, 00186 Roma
Bertolami Fine Art - Piazza Lovatelli 1, 00186 Roma
WEB AUCTION 102 - Arti decorative: ceramiche e vetri del '900 Sessione Unica
giovedì 22 luglio 2021 ore 15:00 (UTC +01:00)
ICS <br>Piatto floreale
ICS
Piatto floreale
d. 18 cm
Buone condizioni, firma sotto la base